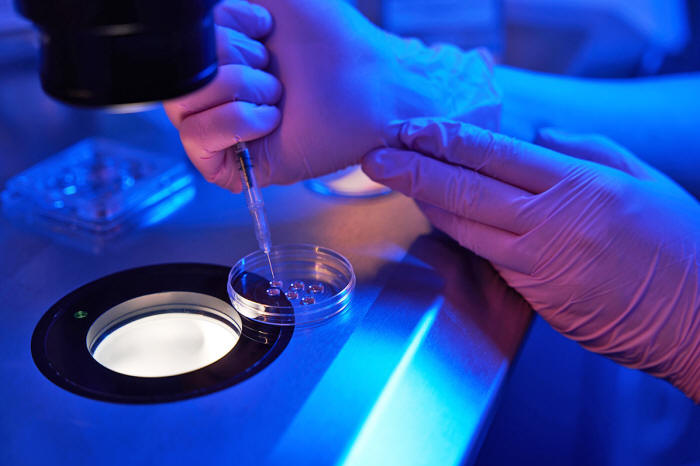

|
20 Ottobre 2025 dal Sito Web StudyFinds
traduzione di Wlady dal Sito Web ItaliaOltre L'embriologo carica gli ovociti con una siringa nella piastra di coltura cellulare. (Foto di Svitlana Hulko su Shutterstock)
Il lavoro è una dimostrazione di laboratorio che mostra cosa potrebbe essere possibile per le persone che non possono produrre ovuli vitali, sebbene permangano notevoli ostacoli scientifici.
Il team dell'Oregon Health & Science University ha utilizzato una tecnica chiamata trasferimento nucleare di cellule somatiche, in cui il nucleo di una cellula cutanea viene inserito in un ovulo donato da cui è stato rimosso il materiale genetico.
Dopo la fecondazione con lo sperma, queste cellule ricostruite hanno prodotto embrioni che si sono sviluppati per diversi giorni
Sebbene puramente sperimentale e ad anni dall'uso clinico, la ricerca (Induction of Experimental Cell Division to Generate Cells with reduced Chromosome Ploidy) pubblicata in Nature Communications mostra una dimostrazione precoce di mitomeiosi,
...che un giorno potrebbe aiutare le donne senza ovuli funzionali ad avere figli geneticamente correlati.
Per le donne, il declino della qualità degli ovociti legato all'età diventa un fattore primario dopo i trentacinque anni e gli attuali trattamenti per la fertilità non possono aiutare coloro che non hanno ovociti vitali.
Come le Cellule della Pelle sono diventate Strutture Simili a Uova
Il processo preleva il nucleo di una cellula della pelle e lo inserisce in un ovulo donato da cui è stato rimosso il materiale genetico, una tecnica chiamata trasferimento nucleare di cellule somatiche o SCNT.
Gli scienziati utilizzano questo metodo da decenni per clonare animali, ma il team dell'Oregon lo ha adattato per uno scopo diverso: creare cellule ricostruite che potrebbero essere potenzialmente fecondate come ovuli naturali.
Quando il nucleo di una cellula epiteliale entra nell'ambiente dell'ovulo donatore, accade qualcosa di inaspettato.
I cromosomi delle cellule della pelle, al contrario, sono copie singole, non duplicate.
Eppure il citoplasma dell'ovulo donatore li induce comunque a formare una struttura pronta per la divisione.
I ricercatori dell'OHSU hanno dimostrato una nuova tecnica per trattare l'infertilità trasformando le cellule della pelle in ovociti, o ovuli. Qui, l'immagine di un ovocita con un'immagine luminosa del nucleo di una cellula della pelle prima della fecondazione. (Crediti: Oregon Health & Science University)
Superare un Ostacolo Importante alla Fertilità
Quando i ricercatori hanno aggiunto sperma a queste cellule ricostruite, la maggior parte è rimasta bloccata.
Gli ovuli naturali sanno come reagire all'ingresso dello spermatozoo: completano la loro divisione e preparano il materiale genetico di entrambi i genitori per la combinazione.
Ma circa tre quarti delle cellule ricostruite si sono semplicemente congelate sul posto.
L'applicazione di un'attivazione artificiale mediante impulsi elettrici e una sostanza chimica chiamata roscovitina ha risolto il problema.
Questo trattamento supplementare ha innescato con successo il processo di divisione, inducendo le cellule a dividere i propri cromosomi tra un pronucleo e un globulo polare scartato, in modo simile al comportamento degli ovuli naturali dopo la fecondazione.
Con questo approccio, circa il 78% delle cellule ha estruso un globulo polare e circa il 76% ha formato due pronuclei:
Cromosomi Ordinati in modo Casuale, non in Coppie Organizzate
Per tracciare cosa accadeva ai singoli cromosomi durante questo insolito processo, i ricercatori hanno reclutato una famiglia con genitori di diversa estrazione etnica.
Hanno utilizzato cellule della pelle della figlia e sperma di un donatore non imparentato.
Leggendo le sequenze di DNA, potevano dire quali cromosomi provenivano dalla madre della figlia, quali da suo padre e quali dal donatore di sperma.
Il team ha esaminato 90 embrioni.
Quando gli ovuli si formano naturalmente, i cromosomi corrispondenti, provenienti dalla madre e dal padre, si accoppiano, si allineano e si separano in modo organizzato.
In queste cellule ricostruite, i cromosomi si sono semplicemente sparsi in modo casuale.
Nel restante 46% degli embrioni non si è verificata alcuna scissione.
La maggior parte ha mantenuto tutti i 46 cromosomi invece di ridurli a 23 come accade negli ovuli naturali.
Tra gli embrioni che hanno effettivamente diviso i loro cromosomi, il numero variava notevolmente.
Un cromosoma si è comportato in modo anomalo.
Il motivo per cui ciò accadesse rimane un mistero...
La Maggior parte degli Embrioni ha smesso di Svilupparsi Precocemente
Quando i ricercatori hanno fecondato le cellule ricostruite e applicato il trattamento di attivazione, la maggior parte si è scissa in cellule multiple.
Tuttavia, solo l'8.8% si è sviluppato in blastocisti, lo stadio in cui gli embrioni vengono tipicamente trasferiti durante trattamento di fecondazione in vitronts.
In confronto, il 59% degli ovuli di controllo normalmente fecondati ha raggiunto questa fase.
L'analisi delle singole cellule ha rivelato composizioni cromosomiche variabili. Alcuni embrioni erano uniformi, con tutte le cellule contenenti la stessa combinazione di cromosomi spermatici e delle cellule cutanee.
Altri erano a mosaico, con cellule diverse che portavano diverse combinazioni cromosomiche.
Quasi tutti gli embrioni contenevano il set completo di 23 cromosomi spermatici, sebbene un embrione a mosaico mancasse di alcuni cromosomi spermatici.
Il numero e l'origine dei cromosomi delle cellule cutanee variavano considerevolmente, creando squilibri cromosomici che probabilmente spiegano perché la maggior parte degli embrioni ha smesso di svilupparsi.
I ricercatori non hanno coltivato embrioni oltre il sesto giorno, rispettando le linee guida etiche per la ricerca sugli embrioni umani.
Anni di Lavoro prima dell'Uso Clinico
Gli scienziati sottolineano che si tratta solo di un esperimento di laboratorio preliminare, non di una cura.
Diversi importanti problemi biologici devono essere risolti prima che questo possa effettivamente aiutare qualcuno.
Il ricercatore capo Shoukhrat Mitalipov ha osservato che il team non è ancora in grado di stabilire se gli embrioni siano falliti a causa di un numero errato di cromosomi o perché il DNA delle cellule della pelle non è stato riprogrammato correttamente per comportarsi come il DNA dell'ovulo.
Probabilmente entrambi i fattori hanno contribuito...
Esperimenti simili sui topi hanno prodotto prole viva, ma la riproduzione nei topi e negli esseri umani funziona in modo sufficientemente diverso, per cui il successo nei topi non garantisce che l'approccio si traduca in realtà.
Se gli scienziati riusciranno alla fine a risolvere questi problemi, questo tipo di tecnica potrebbe aiutare le donne nate senza ovaie o i cui ovuli sono stati danneggiati da trattamenti contro il cancro, condizioni mediche o età.
Al momento, queste pazienti possono utilizzare solo ovuli di donatrice o ricorrere all'adozione.
Un fatto sorprendente:
La ricerca ha ricevuto finanziamenti da,
Le donatrici di ovociti hanno ricevuto un compenso standard per la donazione di ovociti a Portland, Oregon, compreso tra 7,000 e 8,000 dollari, approvato dai revisori etici.
|